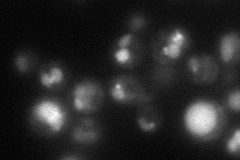
YGL027C
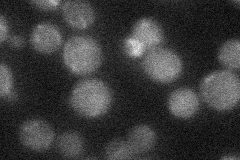
YGL027C

View description
Processing alpha glucosidase I, ER type II integral membrane N-glycoprotein involved in assembly of cell wall beta 1,6 glucan and asparagine-linked protein glycosylation; also involved in ER protein quality control and sensing of ER stress
Localization:
Intensity:
Fold change:
Significance:
-
C’ GFP library in SD

below threshold15.94 -
N' NOP1pr-GFP in SD
vacuole46.3067 -
N' TEF2pr-mCherry in SD

vacuole14.2098 -
N' NATIVEpr-GFP in SD
below threshold19.3893 -
N' TEF2pr-VC and Cyto-VN in SD

#N/A0 -
C’ GFP library in SD+DTT

cytosol15.330.96No -
C’ GFP library in SD+H2O2

cytosol14.890.93No -
C’ GFP library in Starvation Media

cytosol17.131.07No -
C’ GFP library on the background of Pup2-DaMP

below threshold -
C’ GFP library on the background of CCT mutant

below threshold14.7860.926955No
